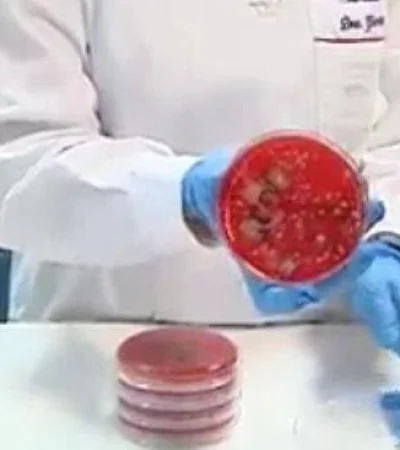
WhatsApp-Image-2020-08-11-at-17.49.59

Un video que muestra los resultados de una investigación hecha por una farmacéutica española se ha hecho viral durante las últimas semanas. La profesional de la salud, Marisa García Alonso, realizó un estudio de cultivo con barbijos de distintas personas para demostrar la gran cantidad de gérmenes y bacterias que se acumulan y, por ende, la importancia de higienizarlos o directamente descartarlos.
Según la autora de este estudio científico, el hecho de llevar puesto el tapaboca repetidas veces por mucho tiempo puede ocasionar infecciones en la boca, la garganta y hasta en los intestinos. "Es como la ropa interior, hay que cambiársela a diario" especifica.
En el video se puede apreciar el impactante cúmulo de bacterias que García recolectó como resultado del cultivo de mascarillas por un sólo día.
"Lo máximo que se tienen que usar son 4 horas" puntualizó la farmacéutica, refiriéndose a las mascarillas quirúrgicas, conocidas por ser parcialmente reutilizables, ya que después de algunos lavados pierden eficacia. Con respecto a las mascarillas EPI (Equipos de Protección Individual), que son las utilizadas por los profesionales de la salud, García afirmó que pueden utilizarse "unas cuantas horas más". Por último, indicó que los tapabocas higiénicos (de tela u otros materiales más gruesos) deben ser lavados con frecuencia.
¿Cómo lavar el barbijo?
"Las podemos rociar con una solución hidroalcohólica y las dejamos bastante limpias" explicó, al ser consultada sobre cómo lavar las mascarillas. A su vez, recomendó dejarlas en bolsas de tela o de papel para conservarlas mientras no las usamos.
Durante una entrevista con un canal televisivo de Córdoba, Marisa dio algunas recomendaciones más acerca de cómo utilizar e higienizar barbijos de forma correcta.
Los barbijos de tela tienen una vida media de lavados que, según sean homologados o no, pueden ser 20 lavados. 20 lavados son 20 días. "Con que hayas tenido el barbijo en la boca 1 hora, ya es suficiente para que se acumulen bacterias". "El dioxido de cloro diluído al 50% con agua destilada higieniza profundamente. Es darle un par de sprays, puede ser una opción". "Puse mi barbijo a lavar a 60 grados en el lavarropas, lo volví a sembrar y comprobé que no había ni una bacteria". "El calor, el vapor y la humedad favorecen a crear colonias de bacterias". "Yo recomiendo mucho mantener la boca saludable. Cepillar normalmente y que esté limpia. Al final, tenemos que evitar que nuestras propias bacterias crezcan".